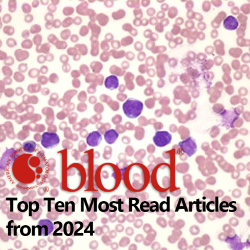
BloodPortfolio's tweet image. 📣 Top 10 most read articles of the year published in Blood! 🏆 
ow.ly/Q8cT50UwB7A
#BloodJournals

Lab Updated
@LabUpdated
Laboratory Medicine Updates in Hematology, Clinical Chemistry and Microbiology
You might like
📣 Top 10 most read articles of the year published in Blood! 🏆 ow.ly/Q8cT50UwB7A #BloodJournals
Development of a novel test of splenic function for use in a clinical diagnostic laboratory onlinelibrary.wiley.com/doi/10.1111/bj…
ESCMID members are invited to review the new version of the “ESCMID manual for clinical practice guidelines and other guidance documents”. Interested persons can visit the website to see how to get a draft. Deadline to provide feedback is 6 January 2025. escmid.org/guidelines-jou…

Multiple Cardiac Biomarkers to Improve Prediction of Cardiovascular Events: Findings from the Generation Scotland Scottish Family Health Study academic.oup.com/clinchem/artic…
Minimal residual disease detection for acute lymphoblastic leukaemia in peripheral blood—Are we there yet? onlinelibrary.wiley.com/doi/10.1111/bj…
English surveillance programme for antimicrobial utilisation and resistance (ESPAUR) report - 2023/2024 gov.uk/government/pub…
“EFLM Cardiac Marker Award for remarkable scientific workin the field of cardiovascular diseases - sponsored by Hytest”

American journal hematology: Comparison of the International Consensus and 5th WHO edition classifications of adult myelodysplastic syndromes and acute myeloid leukemia onlinelibrary.wiley.com/doi/10.1002/aj…
Impact of myelodysplasia-related mutations on 2022 European LeukemiaNet genetic risk classification in de novo acute myeloid leukemia with normal karyotype onlinelibrary.wiley.com/doi/10.1002/aj…
Build figures, presentations, and illustrations with 2,000+ science and medical art visuals. This collection of high-quality, scientifically accurate vectors, icons, and brushes is freely available within the public domain. bioart.niaid.nih.gov
Point-of-care testing, near-patient testing and patient self-testing: warning points degruyter.com/document/doi/1…
November 5th, 2024: European Laboratory day. Let's celebrate!

Molecular taxonomy of myelodysplastic syndromes and its clinical implications ashpublications.org/blood/article/…
The foundation for the microbiology laboratory’s essential role in diagnostic stewardship: an ASM Laboratory Practices Subcommittee report journals.asm.org/doi/10.1128/jc…
Genomic surveillance of resistance and food-borne diseases Free webinar ESCMID: escmid-org.zoom.us/webinar/regist…
United States Trends
- 1. Thanksgiving 369K posts
- 2. Fani Willis 9,454 posts
- 3. Golesh 1,663 posts
- 4. Trumplican 2,499 posts
- 5. Hong Kong 74.4K posts
- 6. Stranger Things 155K posts
- 7. Elijah Moore N/A
- 8. #TejRan 4,092 posts
- 9. Riker N/A
- 10. Pete Skandalakis N/A
- 11. Ruth 13.8K posts
- 12. Khabib 5,640 posts
- 13. Nuns 10.1K posts
- 14. #wednesdaymotivation 6,483 posts
- 15. Karoline Leavitt 27.8K posts
- 16. Tom Hardy N/A
- 17. #Wednesdayvibe 3,437 posts
- 18. NextNRG Inc N/A
- 19. #WednesdayWisdom 1,158 posts
- 20. Ribs 11.5K posts
You might like
-
 Greg
Greg
@GregNowakowski -
 Blood Research
Blood Research
@Blood_Res -
 _dr.uqba
_dr.uqba
@dr_uqba -
 Juda Lebow MD
Juda Lebow MD
@judalebow -
 Altium Cares
Altium Cares
@AltiumCares -
 Prof MKarim.MACP.MCPS.FCPS. Clinical Fellow,NUH,SG
Prof MKarim.MACP.MCPS.FCPS. Clinical Fellow,NUH,SG
@karim_mostafiz -
 Kiavasch Farid
Kiavasch Farid
@KFHemeOnc -
 Gareth Gregory
Gareth Gregory
@DrGarethGregor1 -
 Elena van Leeuwen
Elena van Leeuwen
@Elena_vLeeuwen -
 Gettesfaw
Gettesfaw
@gettesfaw -
 Md Abu Hanif Edan
Md Abu Hanif Edan
@Edan19952
Something went wrong.
Something went wrong.


















































































